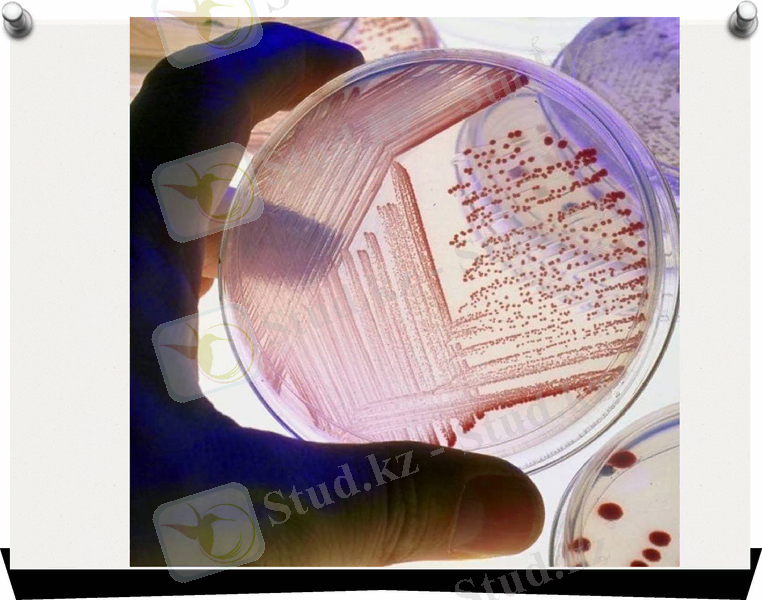
Slide 9

Клебсиелла мен Proteus бактериялары: қасиеттері, патогенезі, клиникасы және диагностикасы



Клебсиеллез және протоез

Klebsiella туыстығы Enterobacteriaceae тұқымдасына жатады. (неміс бактериологі Э. Клебс ашқан) . Klebsiella капсула түзбейді. Klebsiella туыстығы бірнеше түрлерден тұрада: K. pneumoniae K. ozaenae K. rinoscleromatis Клебсиеллалар әрдайым адам мен жануарлалардың терісі мен шырышты қабаттарында анықталады. K. pneumoniae - аралас инфекциялалардың қоздырғышы болып табылады.



Клебсиеллалар - Грамтеріс шеттері дөңгелектенген жуан таяқшалар, мөлшерінің өзгеруіне байланысты капсуласыз клебсиеллалалардың мөлшері-0, 3-0, 6, 5-6, 0 мкм, ал капсулалы клебсиеллалалардың, көбінесе K. pneumoniae, мөлшері мкм, спора және талшықтарды түзбейді, штаммдардың жартысында кірпікшелер болады. Жуан полисахаридтті капсулалар айқын көрінеді. Төменгі температуралардың, өттің, антибиотиктердің, мутагендердің сарысудың, фаггтардың әсерімен капсулалы формаларын бөліп алуға болады. Жалғыз немесе жұптасып орналасады

Факультативті анаэробтар,, хемаорганотроф, өсу температурасы 12°С дан 41°С дейін, оптимумы 35-37°С, рН 7, 2-7, 4. Симмонс ортасында өсуге қабылеті бар, яғни жалғыз көміртек көзі ретінде натрии цитратың қолданады (K. rinoscleromatisтың басқалары) . Тығыз қоректік ортада лайланған клегейлі колония түзбейді. Озен бактериялары 2-4 сағатта жайылған-жинақы қатар болып,
р и о с к л е р о м а - жинақы, пневмония- ілмек тәрізді орналасады. ЕПС- да бірқалыпты лайланып, кейде бетінде қабықша пайда болады. Клебсиеллалар көмірсуларды қышқылға немесе қышқылмен тұзға дейін ферменттейді, нитратты нитритке айналдырады. Желатинді сұйылтпайды, индол мен күкіртсутегін түзбейді, уреазды активтілікке ие, кейбірде сүтті ұйытады. Риноскелерома қоздырғышының биохимялық активтілігі төмен. О-және К-антигендері болады. Негізгі патогенді факторы фагоцитозды тежейтін К-анитигендері және эндотоксин болып табылады. Пневмония клебсиеллалары, қосымша термолабильді энтеротоксин өндіреді, олар біріншіден ақуыз, екіншіден әсер етуі бойынша ішек таяқшасының энтеротоксиніне ұқсас.

Клебсиеллез көбінесе ішкілік инфекция ретінде кездеседі, инфекцияның көзі ауру жануар немесе бактериотасымалдаушы. Экзогенді және эндогенді жолмен жұғуы мүмкін. Жиі азық, ауа- тамшы, қарым-қатынас арқылы жұғады, көптеген антибиотиктерге тұрақты. Дезинфекциялық заттарға сезімтал, қоршаған ортаның әсеріне тұрақы.
Патогенезі және клиникасы K. pneumoniae ішек инфекциясына ұқсас ауру шақырады. 1-5 тәулікке дейін ауру созылады. Клебсиеллалар тыныс алу жолдарын, буынның, мидың қабынуы, конъюнктиваның жынысты-зәршығару ағзаларының қабынуын, сепсис, операциадан кейінгі асқынулар тудырады, аурудың Генеризацияланған сепитико- пиемиялық түрі кейде өлімге алып келеді.

K. ozaenae танаудың шырышты қабатын және оның қосалқы кеңістігінде, атрофиясын шақырада, қабыну барысында жағымсыз иісті бөлінді бөлінеді. K. rinoscleromatis мұрынның шырышты қабатын ғана. емес, трахеяны, бронхты, жұтқыншақты, аңқаны жарақаттайды, осы жағдайда жарақатталған ұлпада, шеміршек тәрізді инфильтратқа алып келетін арнайы гранулема пайда болады. Ауру созылмалы түрде жүреді, трахеяны, аңқаның кепгелінің (обтурациясының) нәтижесі өлімге алып келеді.

Клебсидиагностикасы. Микробиологиялық диагностикасында ең қолайлысы бактериологиялық тәсіл. Зерттелетін материалдар: ірің, қан, ликвор, нәжіс заттардың жуындысы және т. б. болып табылады. Дифференциалды-диагностикалық ортада К-2 (мочевинамен, рафинозамен, бромтимол кегімен), бір тәуліктен кейін, сары, немесе жасыл-сарыдан ауа көкке дейін, үлкен, жылтыр, клегейлі колониялар өсіп шығады. Одан кейін Пешков ортасына егіп, бактериялалардың қозғалғыштығын және орнитиндекарбоксилаза бар екендігін анықтайды. Бұл қасиеттер клебсиеллаларда болмайды. Соңғы идентификацияны биохимиялық қасиеттері және тірі дақылды К-сарысумен агглютинация реакцияның көмегімен серотопан анықтау арқылы жүргіземіз. Бөлінген дақылдың антибиотиктерге сезімталдығын тексереді. Клебсиеллездың диагностикасында кейбір жағдайда стандартты О- клебсиеллезды антигенмен немесе аутоштаммен агглютинация реакциясын және КБР жүргізеді. Антидененің титрынің төрт есе өсуінің диагностикалық маңызы бар.

Алдын алуы және емі: Клебсиеллездарды стационарларда емдейді. Ішектің жарақаттаррында антибиотиктер қолданбайды. Сусызданған жағдайда (энтеротоксиннің әсері) пероральды немесе парентеральды жолдармен газды ергінділер қ олданады. Генерелизацияланған жағдайда және созылмалы түрлерде антибиотиктерді қолданады (антибиотиктерге сезімталдығын тексергеннен кейін), аутовакциналар; иммунитетті көтеруге бағытталған қызмет жүргізіледі (аутогемотерапия, пирогенотерапия т. б. ) . Арнайы алдын алу жоқ, жалпы профилактикаға санитарлы-гигеналы қ ережелерді қатаң сақтау жатады


Ішек инфекциясы - протеозды Proteus бактериясы тудырады. Көбіне, асқазан-ішек жолдарының зақымдалуымен, гастроэнтеритпен және энтероколитпен сипатталады.


Этиологиясы
Ішек инфекциясының қоздырғыштары - граммтеріс, полиморфты таяқшалар, факультативті анаэробтар, спора мен капсула түзбейді, Enterobacteriacaea тұқымдасына жатады. Микроб екі антигеннен тұрады: О-антиген және Н-антиген.

Патогенезі
Бұл ауру дисбактериоздан туындауы мүмкін. Азықтық токсикоинфекциядан ауыр инфекциялық аур пайда болады, аурудың патогенезінде басты себепкер эндотоксин болады, ішектегі пртеиндік микробтардан ажырап, зақымдайды.
- Іс жүргізу
- Автоматтандыру, Техника
- Алғашқы әскери дайындық
- Астрономия
- Ауыл шаруашылығы
- Банк ісі
- Бизнесті бағалау
- Биология
- Бухгалтерлік іс
- Валеология
- Ветеринария
- География
- Геология, Геофизика, Геодезия
- Дін
- Ет, сүт, шарап өнімдері
- Жалпы тарих
- Жер кадастрі, Жылжымайтын мүлік
- Журналистика
- Информатика
- Кеден ісі
- Маркетинг
- Математика, Геометрия
- Медицина
- Мемлекеттік басқару
- Менеджмент
- Мұнай, Газ
- Мұрағат ісі
- Мәдениеттану
- ОБЖ (Основы безопасности жизнедеятельности)
- Педагогика
- Полиграфия
- Психология
- Салық
- Саясаттану
- Сақтандыру
- Сертификаттау, стандарттау
- Социология, Демография
- Спорт
- Статистика
- Тілтану, Филология
- Тарихи тұлғалар
- Тау-кен ісі
- Транспорт
- Туризм
- Физика
- Философия
- Халықаралық қатынастар
- Химия
- Экология, Қоршаған ортаны қорғау
- Экономика
- Экономикалық география
- Электротехника
- Қазақстан тарихы
- Қаржы
- Құрылыс
- Құқық, Криминалистика
- Әдебиет
- Өнер, музыка
- Өнеркәсіп, Өндіріс
Қазақ тілінде жазылған рефераттар, курстық жұмыстар, дипломдық жұмыстар бойынша біздің қор #1 болып табылады.



Ақпарат
Қосымша
Email: info@stud.kz